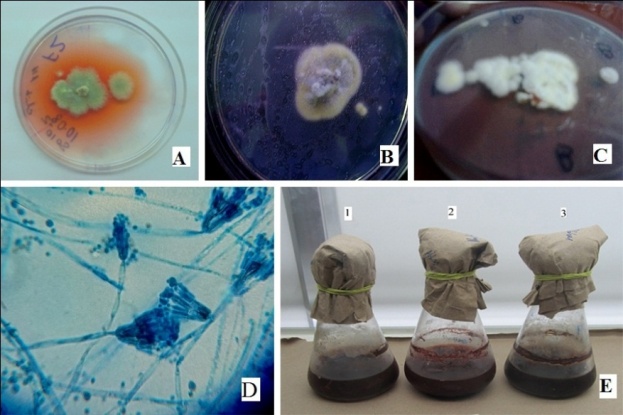
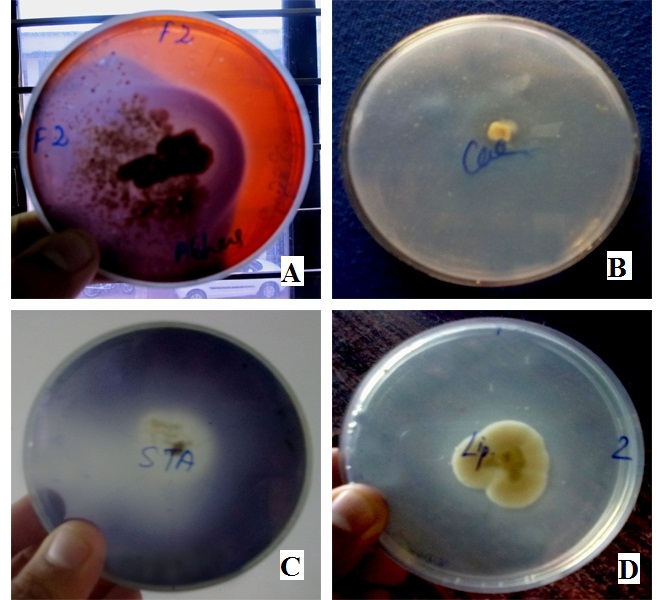

Polar Biology, National Centre for Antarctic and Ocean Research, Headland Sada, Vasco-da-Gama, Goa 403804, India
Email: abhas_maharana@yahoo.com
Received: 14 Jun 2016 Revised and Accepted: 12 Aug 2016
ABSTRACT
Objective: The objective of the present study was on Penicillium pinophilum strain F2 from soil samples of Jammu city having the potentiality to produce alkaline cold active endoglucanase and pigment.
Methods: Penicillium pinophilum strain F2, a psychrotolerant micro-fungus was isolated from soil of Jammu city, India by taking Czapek’s Dox agar incubated at 15 °C. The strain was screened for production of cold active enzymes by taking various substrates at 15 °C. Final production was done for cold active endoglucanase by using sugarcane bagasse and ground nut shell as substrates. Besides, the strain was also able to produce red color pigment at a low temperature which was further studied to optimize its production by changing pH and growth medium. The produced pigment was used for dyeing of wool and silk, and absorption percentages were also calculated.
Results: Screening for the production of cold active enzymes revealed it as a good producer of cellulose followed by lipase and amylase. Endoglucanase production revealed the total enzyme titer (total enzyme activity) was found to be 5.032 folds higher in sugarcane bagasse (38.91 units) than groundnut shell (7.732 units). Endoglucanase activity was maximum 9.82±0.33 units/ml and 2.29±0.31 units/ml after 120 h of incubation at 15 °C by sugarcane bagasse and groundnut shells, respectively. Red color pigment production was maxima at pH 5 in Czapek’s Dox broth. Maximum absorption percentage was seen by the treatment soaked with mordant, i.e. 5% CuSO4 (51.52%) and without a mordant, it showed about 45.54%.
Conclusion: Due to the above unique features and capability to produce cold active endoglucanase and pigment by strain F2, can be used significantly in various industries.
Keywords: Cold active, Endoglucanase, Natural dye, Penicillium pinophilum strain F2, Psychrotolerant, Textile dyeing
© 2016 The Authors. Published by Innovare Academic Sciences Pvt Ltd. This is an open access article under the CC BY license (http://creativecommons. org/licenses/by/4. 0/)
DOI: http://dx.doi.org/10.22159/ijpps.2016v8i10.13441
INTRODUCTION
Metabolites, end product of metabolism, may be primary or secondary. Primary metabolites are meant for the cell growth and proliferation whereas secondary metabolites have some economic importance.
Enzymes are the primary metabolites produced from microorganisms at log phase, and extremozymes are seen to have immense future applications in various fields of science. There is a high demand of cold active enzymes in food and beverages, detergent and textile industries. To fill the requirement, there is a necessary to investigate on cold active microorganisms capable of producing cold enzymes. Carboxymethyl cellulases (CMCase) or endoglucanases (EGs) (β-1,4-endoglucanase, EC 3.2.1.4) are inducible enzymes that are synthesized by microorganisms during their growth on cellulosic materials. EGs have many industrial applications, can be used to remove unwanted extra fibrils from clothes [1] and can also save energy consumption during the saccharification of cellulose slurry at a low temperature in spite of doing at higher temperature i.e. 60-70 °C [2]. Most reports of EGs were from fungi rather than bacteria. Production of cellulase by Penicillium purpurogenum was investigated [3]. However, there are few reports on Cold Active Endoglucanases (CAEGs) from either fungal [2, 4-9] or bacterial [7, 10] origins. Penicillium spp. are known to be good producers of useful enzymes that degrade cellulose, proteins, xylan, starch, lipids, etc. [11]. Besides, Yoon and co-workers reported about a total of 106 Penicillium spp. for the enzymatic degradation ability on various substrates, where Penicillium purpurogenum showed strong activity for xylanase and β-Glucosidase but no activity of pectinase was found [12].
Pigments are the secondary metabolites produced by micro-organisms at stationary phase having great economic importance. Many microorganisms could be able to produce pigments only when in cold temperature, that’s why most psychrotolerants and psychrophiles are pigmented. Pigments can be used in various industries like the food industry where it can be used as additives, color intensifiers, and anti-oxidants. Natural dyes can be obtained from many sources like plants and animals. Even so, due to their low water solubility and instability, microbes have recently received focus as sources of natural pigments. Many fungal species produce pigments [3]. The genera Aspergillus and Penicillium were regarded as potential producers of natural pigments [14-18].
Though all Natural dyes are not 100% safe, they are less toxic and higher productive than their synthetic counterparts. Many of the Natural dyes like turmeric, annatto and saffron are permitted as food additives. Natural dyes are biodegradable and cost effective. The isolation and characterization of Penicillium spp. capable of producing red pigments were also studied [19, 20]. There are many factors, which affect the hyper-production of pigments like pH, temperature and media composition.
The present study was emphasized on the quantification and application of pigment produced by a psychrotolerant Penicillium pinophilum at cold temperature and also studied the potentiality to produce cold active endoglucanase using solid-state fermentation technique.
MATERIALS AND METHODS
Isolation and identification of psychrotolerant micro-fungi
For the isolation of psychrotolerant micro-fungi, soil samples collected from Jammu city (32 ° 43′ 48″ N, 74 ° 52′ 12″ E) were spread on sterilized Czapek’s Dox agar with streptomycin sulfate (0.015%) by serial dilution technique and incubated at 15±1 °C. The isolated fungi were then revived again on Czapek’s Dox agar slants and maintained at 4 °C. Pure cultures of isolated fungi were identified based on their micro-and macro-morphology [21, 22]. Micro-morphological identification was done by lactophenol cotton blue and observed under the phase contrast microscope (LAS EZ version 1.5.0) both at 40X and 100X. The isolated fungi were grown on different agar media (Sabouraud dextrose agar (SDA), Czapek’s Dox agar (CDA), Potato dextrose agar (PDA) and Malt extract agar (MEA)) and investigated for its accurate identification and characterization. Besides, it was investigated for growth at varied temperature, pH, salt tolerance test and urease production.
Screening for extracellular enzymes
The productions of cold active extracellular enzymes were determined by inoculating isolated psychrotolerant microfungi in respective pseudo agar media with specific substrates. Each plate was incubated at various temperatures of 15 °C and 30 °C in triplicates. Zones of clearing around the fungal colony were measured in mm as the difference between the total diameter of the halo and the colony. For the lipolytic activity, the micro-fungi was spotted inoculated on a medium having tween-80, CaCl2 and the formation of the precipitate around the colony were regarded as positive for lipase [23]. Cold active protease was determined by taking 1% casein and 1% gelatin in 1/5th of nutrient agar medium separately. Amylase test was done by using 1/5th of nutrient agar with 1% soluble starch. Cellulase test was done by using nutrient agar with 0.2% carboxymethylcellulose with Congo red [24]. The ability of the micro-fungi to hydrolyze pectin into pectic acid was assayed by taking 1/5th nutrient agar with 1% pectin. For each test, pure and young cultures were taken and incubated at respective temperatures in BOD incubator for 5 d.
Molecular identification of potent fungal isolate
Molecular identification of the potent isolate producing cold active endoglucanase was done by using D1/D2 region of LSU (Large Sub Unit: 28S rDNA) based molecular technique, which was outsourced (Xcleris Labs Ltd., Ahmadabad, India). The gene sequence was used to carry out BLAST with the nr database of GenBank database. The Consensus Sequence was submitted at BankIt, GenBank, NCBI for the accession number.
Cold active endoglucanase production
About 10 g of each sugarcane bagasse and ground nut shells were taken in 250 ml Erlenmeyer flasks moistened with a mineral salt solution [2]. The initial moisture content was maintained at 75% and inoculated with an inoculum of 10% (v/w of substrate used) after autoclaving at 121 °C for 60 min. The contents of the flasks were mixed thoroughly to ensure uniform distribution of the inoculum which was incubated at 15±1 °C for 192 h.
Extraction and quantification of cold active endoglucanase
The enzyme from the fermented medium was extracted employing simple contact method with citrate buffer (0.05 M, pH 4.8) in a substrate: buffer ratio of 1:10 [25]. The flasks were shaken at 150 rpm for 30 min at 15±1 °C. Then all extracts were filtered by Whatman filter paper no. 1 for the removal of substrates and fungal mycelia. Then filtrates were centrifuged at 10,000 rpm for 20 min at 4 °C. The clear supernatants obtained were considered as crude enzyme and endoglucanase activity was determined by estimating the reducing sugar produced during the enzymatic reaction by 3,5-dinitrosalicylic acid (DNS) method with slight modifications [26]. Crude enzyme assay was done at 15±1 °C which was incubated for 20 min. After incubation, 1.5 ml DNS was used to stop the reaction and boiled for 10 min and absorbance was taken at 540 nm against enzyme-free medium and respective sample blanks were also considered. One unit of activity is the amount of enzymes required to release 1.0 µmol of reducing sugar (as glucose) per minute under the described conditions [27].
Pigment production and quantification
As the same isolate produced extracellular red pigment on Czapek’s Dox (CD) agar, the isolate was again checked for the hyper-production of pigment by taking the above medium in broth incubated at 15 °C and 165 rpm. The pigment production was optimized by taking parameters like incubation period, initial pH, and different media like Czapek’s Dox broth (CDB), Malt extract broth (MEB) and Potato dextrose broth (PDB). After incubating the culture in respective conditions, 5 ml of broth was withdrawn in the interval of 5 d. It was centrifuged at 10,000 rpm for 10 min at 4 °C. The supernatant collected was separated from the palette and absorbance was calculated at 482 nm. The palette (biomass) collected was kept on hot air oven at 60 °C for overnight and dry weight was calculated. Final pH and conductivity of all treatments were calculated. The yield of pigment was calculated as follows [20]:
YP/X = (Pt/Xt)(P0/X0)
Where, YP/X denoted pigment yield per unit biomass, P0, Pt and X0, Xt denoted pigment produced and biomass generated in a certain time (t) respectively.
Application of pigment textile dyeing
For this purpose, white wool and silk fabrics were collected from the local market, and the colored supernatant was directly used for dyeing. One set of silk fabric sample and wool samples were soaked with 5% CuSO4, and another set was directly used without any mordant. It was done so, whether the studied pigment was requiring mordant for dyeing or not. Both treated and untreated samples were applied in 20 ml colored supernatant for 1 h at 80 °C then allowed drying. After drying it was washed with cold water. Absorption percentage was calculated spectrophotometrically at 482 nm by the following [28]:

Where, OD482B had denoted as the optical density of the sample before dyeing and OD482A denoted as the optical density of the sample after dyeing.
Statistical analysis
The data recorded during the investigation was subjected to Pearson’s correlation coefficient determination (r), Student’s T-test and Analysis of Variance (ANOVA), and the conclusions were drawn accordingly.
RESULTS AND DISCUSSION
Identification and characterization of the micro-fungus
The isolated fungus was identified as Penicillium sp. by its micro-and macro-morphological features, which showed slow growth, greenish white, velvety colony from front but the back side was yellowish to orange on PDA and MEA medium, and on SDA medium, it showed moderate growth, olive-green margins with centre white, velvety appearance from the front view and yellowish from back side of the colony. On Czapek’s Dox media, this species showed rapid growth, the light green border with central deep green, powdery appearance while the back side of the colony was reddish in color (fig. 1).
Fig. 1: Pigment producing Penicillium pinophilum strain F2 at 15 °C. A-C: Growth on CDA, SDA and PDA respectively; D: Lactophenol cotton blue staining; E (1-3): pigment production using various broths i.e. CDB, MEB and PDB respectively
It showed aerial smooth hyphae and conidia were an ellipsoidal, thick wall. All the morphological characteristics were in accordance with the findings [29]. This strain was identified as Penicillium pinophilum strain F2 having accession no. KT900148 (fig. 2). This strain was also able to grow at 10 °C but it is negative for urease production. It can tolerate a pH of 9.5 and 10% NaCl concentration for growth, which denoted the strain as halo-alkali tolerant micro-fungus.

Fig. 2: Neighbor-joining tree based on D1/D2 region of LSU (Large Sub Unit: 28S rDNA) molecular technique showing the position of strain F2 in relation to the type species of the genus Penicillium. GenBank accession numbers for the sequences are shown in parentheses. Numbers at nodes denote bootstrap values based on 1000 replicates
Screening for cold active extracellular enzymes by strain F2
This strain was a good producer of cold active cellulase followed by lipase, and amylase (fig. 3). Besides, it could able to degrade pectin and casein little extent, but there was no zone of clearance in gelatin assay medium. The present study is in accordance with the reports of endoglucanase production by Penicillium sp. at 20 °C [3, 4, 12].
Fig. 3: Enzymatic plate assay of Penicillium pinophilum strain F2 at 15 °C, a: Cellulase, B: Caseinase, C: Amylase, D: Lipase
Production of cold active extracellular enzymes
The quantification study revealed that the best substrate for endoglucanase production is sugarcane bagasse (fig. 4). The maximum activity was seen on 120 h of incubation at 15 °C. There is a positive and significant correlation observed in each substrate between the incubation period (p<0.05). T-test also revealed significant differences between the population means (p<0.05). The total enzyme titer (total enzyme activity) was found to be 5.032 folds higher in sugarcane bagasses than groundnut shell.
Sugarcane bagasses contain 40% cellulose [30] whereas groundnut shells contain 35.7% cellulose [31] which account for the variation of endoglucanase production by using the above two solid substrates. In addition to that adsorption of enzymes and the formations of the enzyme-substrate complex are considered to be a critical process in the enzymatic hydrolysis of cellulose. Fibers of cellulose contained both amorphous and crystalline regions and considered to be more difficult to be degraded than the amorphous regions [32]. The highest productivity of cellulase with sugarcane bagasses may be due to the most amorphous forms of cellulose to be degraded efficiently [33].

Fig. 4: Effect of incubation period on cold active endoglucanase production by Penicillium pinophilum strain F2, ANOVA revealed that there is a high significant difference between the two substrates investigated (p<0.001)
The study revealed that there was an increase in the production at initial phase, which was due to the abundance of nutrients and no growth inhibitors. The reduction in endoglucanase yield after an optimum period is probably due to the depletion of nutrients or may be due to pH change of the medium. Endoglucanase is capable of hydrolyze the amorphous regions of the cellulose fibrils by random cleavage of β-glycosidic bonds. Hydrolysis rates of substrates decline with time may be due to depletion of the more amorphous substrates, product inhibition and enzyme inactivation [27]. Endoglucanase production was ceased, which might be due to liberation of glucose subunits in the medium, responsible for feedback inhibition [34]. Fungi are aerobic in nature. As all the endoglucanase production was performed in a static condition, the oxygen supply in the production medium became less, and the production decreased at a later stage of incubation.
Pigment production optimization
An extracellular red color pigment was also produced on CD agar plate at 15 °C after 5 d of incubation. After observing the pigment production on CD agar plate, quantification of pigment was done by using various media. In total six treatments were taken with different in media composition and pH (table 1).
Table 1: Different parameters affecting pigment production and yield at 15 °C
| Treatment | Media | Conductivity (µS/cm) | Initial pH | Final pH | Pigment production (OD units) | Biomass (g/l) | YP/X |
| T1 | CDB | 1600±20 | 9±0.1 | 3.30±0.1 | 0.6409±0.12 | 3.74±0.11 | 0.17±0.027 |
| T2 | MEB | 740±10 | 7.5±0.1 | 6.54±0.08 | 4.1953±0.33 | 6.46±0.32 | 0.65±0.019 |
| T3 | PDB | 380±20 | 7.5±0.1 | 4.88±0.04 | 2.0277±0.01 | 5.48±0. 27 | 0.37±0.016 |
| T4 | CDB | 1400±20 | 5±0.1 | 3.70±0.1 | 4.1914±0.18 | 4.42±0.11 | 0.95±0.017 |
| T5 | CDB | 1500±30 | 7±0.2 | 3.40±0.2 | 3.4001±0.36 | 5.36±0.55 | 0.63±0.002 |
| T6 | CDB | 1440±20 | 7.5±0.1 | 3.18±0.1 | 2.2446±0.14 | 2.9±0.13 | 0.77±0.013 |
CDB: Czapek’s Dox broth, MEB: Malt extract broth, PDB: Potato dextrose broth, YP/X: pigment yield per unit biomass, All values are mean±SD, Sample size, n=3
Effect of pH on pigment production
The pigment production was not only affected by various medium compositions; the pH of the medium also has a great impact. Acidic medium of CDB and slight alkaline medium of MEB were the best for pigment production (table 1). Initial pH has a negative and significant correlation with pigment production (r=-0.77) and pigment yield (r=-0.85), but insignificant with fungal biomass (r=-0.12). It revealed that decrease in initial pH of the medium, there will be increased in pigment production and yield. However, it cannot be applicable for fungal biomass. There was a decline in pH of the production broth during the fungal growth, which was also reported by many authors [28, 35]. There was a negative and significant correlation (r =-0.82) among the initial and final pH of the CDB medium. The present study was contradicted with the study of Sharma and co-workers [28] if CDB was concerned. They reported maximum pigment production in alkaline pH 9 of the medium (YP/X= 0.8401). There was another report of the higher production of red pigment at pH 9 by Penicillium sp. [36]. There were many reports [37, 38] of producing red pigments by Monascus sp. at pH 5.5 which was in accordance with our present study.
Effect of incubation period and media composition on pigment production
Pigment productions in all treatments were maximum on 20 d of incubation at 15 °C after which OD units were stabilized (fig. 5). Among the six treatments, T1 gave the least pigment (0.6409 OD units), whereas T2 and T4 were high producers of pigment 4.1953 and 4.1914 OD units respectively.

Fig. 5: Effect of incubation period on different treatments (T1-T6) for pigment production by Penicillium pinophilum strain F2 and values are mean±SD for three distinctive experiments, n=3, ANOVA revealed that there is a significant difference between the treatments with incubation period (p<0.05)
Effect of medium on pigment production
Three types of media were used. Among them, MEB was regarded as the appropriate medium for pigment production and fungal biomass, but pigment yield was maximum in case of CDB (YP/X= 0.95, T4). Pigment production was insignificantly correlated (r= 0.54) with fungal biomass, which replies both the factors were independent of each other, and higher biomass should not necessarily produce higher pigments.
Characteristics of pigments
As we already discussed pigment production, and yield varies among the treatments, conductivity of the pigment samples was also determined. Higher conductivity was shown in the case of CDB than other two media used in this study. T1 showed maximum 1600 µS/cm conductivity whereas less was shown in the case of T3 (PDB). All the treatments were also checked for their absorbance peaks. Results revealed that the absorbance peaks of all treatments T1-T6 were 402 nm (1.6376 OD units), 405 nm (4.4344 OD units), 405 nm (4.4324 OD units), 482 nm (4.1914 OD units), 482 nm (3.4001 OD units) and 402 nm (2.7297 OD units) respectively.
Absorption percentage of dyed samples
An equal amount of silk and wool samples were treated with each treatment (T1-T6) for dyeing. Absorption percentage was calculated and was the maximum in T6 i.e. 51.52% (treated with mordant) and 45.54% (untreated) followed by T5 (fig. 6). Least absorption was done in the case of T2.

Fig. 6: Absorption percentage at 482 nm and values are mean±SD for three distinctive experiments, n=3, ANOVA revealed that there is a significant difference between the treatments in absorption percentages (p<0.01)
From fig. 7 A: it can be revealed that medium plays an important role in pigment color intensity as PDB and MEB gave darker color than CDB. Soaking with 5% CuSO4 enhanced the pigment absorption by the dye samples among all treatments which can also visually analyze in fig. 7B-G. There was a positive and significant correlation (r= 0.88) among the absorption percentage of both mordants treated and untreated samples.

Fig. 7: A. Pigments after removal of fungal biomass (T1-T6); B-G: Dyed samples (T1-T6) with control, T: treated with mordant; UT: untreated
CONCLUSION
The pigment produced by the psychrotolerant micro-fungus Penicillium pinophilum strain F2 can be used for dyeing purpose. Besides, it is a good producer of cold active endoglucanase. The production of pigment depends on the medium composition and its initial pH. Pigments have no sign of irritation to human skin. It was seen that mordant enhances the pigment absorption capacity of the dyed samples, but untreated samples also show a significant percentage of absorption. Nowadays there is a high demand of natural dye which can be fulfilled by the above-mentioned micro-fungus and pigments can be produced in large-scale and also used in textile industries. The potential application of Penicillium pinophilum strain F2 due to the relative high production of endoglucanase at a low temperature can be used in detergent or textile industries thereby making it possible to reduce temperature and energy costs.
ACKNOWLEDGEMENT
The author would like to thank the Head, Department of Microbiology, C. B. S. H., Orissa University of Agriculture and Technology, Bhubaneswar, for the laboratory support and Dr. (Mrs.) Pratima Ray, Associate Professor, Department of Microbiology, C. B. S. H., Orissa University of Agriculture and Technology, Bhubaneswar, for guidance and motivation.
CONFLICTS OF INTERESTS
Author has none to declare
REFERENCES
How to cite this article